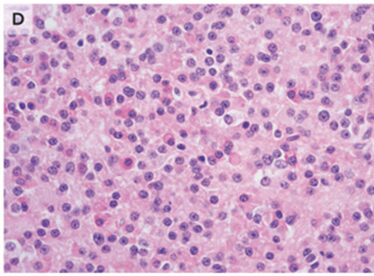

- 2025年10月31日
- 2025年12月22日
先端巨大症:糖尿病性ケトアシドーシスがきっかけで診断された症例ですが、耐糖能異常や血圧高値と顔貌から疾患を想起します。
34歳男性。糖尿病性ケトアシドーシス(DKA)で入院してきたところ、「顔が特徴的(広がった鼻・前頭部の隆起・突出した下顎・上切歯の不整咬合)」であることに代謝内分泌科医が気づいた(A)。
15年前の画像(B)とは異なっていた。

特記すべき既往はないが、過去10年間で靴のサイズが3cm大きくなったことが分かった。
視野もぼやけてきたとのことであった。視野検査では両耳側半盲が判明した。
舌も巨大であった。
採血検査ではHbA1c 12.3%、IGF-1(インスリン様成長因子1) 478 ng(参考範囲 53~331)、GH>65(参考範囲≦7.1)であった。
頭部MRIでは60mm×34mm×28mmの下垂体巨大腺腫を認めた。

径蝶形骨主要部分切除術が施行された。組織病理検査ではGH染色陽性腺腫が示された。
残存腫瘍を治療するため、毎月オクトレオチド(ソマトスタチンアナログ製剤:下垂体腺腫細胞からのGH放出を抑制)を投与するよう指示され、糖尿病と高血圧の治療薬を服用して退院となった。
1か月後のフォローではIGF-1レベルは低下したが、主流派徐々に再拡大をし、最初の手術から8か月後に2回目の切除術が施行された。
N Engl J Med 2023; 388:70
DOI: 10.1056/NEJMicm2205570
柏五味歯科内科リウマチクリニック
ホームページ